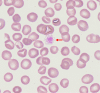

Acute Coronary Syndrome Developed in a 17-year-old Boy with Sitosterolemia Comorbid with Takayasu Arteritis: A Rare Case Report and Review of the Literature
- PMID: 34615826
- PMCID: PMC9107993
- DOI: 10.2169/internalmedicine.8288-21
Acute Coronary Syndrome Developed in a 17-year-old Boy with Sitosterolemia Comorbid with Takayasu Arteritis: A Rare Case Report and Review of the Literature
Abstract
A 17-year-old boy with acute coronary syndrome was admitted to our hospital. He had xanthomas over his elbow and Achilles tendon and a high level of low-density lipoprotein cholesterol; therefore, his initial diagnosis was familial hypercholesterolemia. However, a genetic analysis revealed a compound heterozygous mutation in the ABCG5 gene with a high serum level of sitosterol, leading to the diagnosis of sitosterolemia. After lipid-lowering treatment, percutaneous coronary intervention was performed. Furthermore, a persistently high C-reactive protein level and images of large arteries led to a diagnosis of Takayasu arteritis. To our knowledge, this is the first case of sitosterolemia complicated by Takayasu arteritis.
Keywords: ABCG5; C-reactive protein; heterozygous mutation; low-density lipoprotein cholesterol.
Conflict of interest statement
Figures

References
Publication types
MeSH terms
Substances
Supplementary concepts
LinkOut - more resources
Full Text Sources
Medical
Research Materials